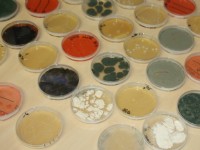

Artikelen: toelating gewasbeschermingsmiddelen (CTGB)
Overzichtspagina artikelen: 'toelating gewasbeschermingsmiddelen (CTGB)' op Nieuweoogst.nl. Voor overige onderwerpen kunt u onze zoekfunctie (rechtsboven) gebruiken of bekijk het nieuwsarchief.
-
Ctgb laat vier middelen toe in land- en tuinbouw
28-12-2017 - Het College voor de toelating van gewasbeschermingsmiddelen en biociden (Ctgb) heeft op 20 december besloten tot de toelating van vier nieuwe gewasbeschermingsmiddelen.
-
Gratis opschonen van de middelenkast
21-12-2017 - Boeren kunnen veilig en kosteloos restanten van gewasbeschermingsmiddelen op laten halen door mee te doen aan de actie 'Bezem door de middelenkast'.
-
Ctgb wil graag meer groene middelen beoordelen
19-12-2017 - Directeur Luuk van Duijn van het Ctgb wil de drempel voor toelatingsaanvragen van groene gewasbeschermingsmiddelen verlagen. 'Potentiële aanvragers moeten niet denken dat wij een onneembaar...
-
Drie nieuwe middelen toegelaten in granen
24-11-2017 - Het College voor de toelating van gewasbeschermingsmiddelen en biociden (Ctgb) heeft deze week drie middelen toegelaten in granen.
-
Tracer in drie nieuwe teelten toegelaten
23-11-2017 - Op verzoek van LTO Glaskracht Nederland is het gebruiksgebied van het middel Tracer uitgebreid met de bedekte teelt van radijs, de bedekte en onbedekte teelt van sierkool en de onbedekte...
-
Ctgb laat twee nieuwe middelen toe
27-10-2017 - Het College voor de toelating van gewasbeschermingsmiddelen en biociden (Ctgb) heeft deze week twee nieuwe gewasbeschermingsmiddelen toegelaten: Sulcotrek en Kumulus.
-
Soepeler criteria voor laag-risicostoffen
07-09-2017 - De Europese Commissie stelt nieuwe criteria vast voor de toelating van laag-risicostoffen. Doel is het gebruik van deze stoffen stimuleren.
-
Ctgb laat Property 180SC en Metric toe
31-07-2017 - Het College voor de toelating van gewasbeschermingsmiddelen en biociden (Ctgb) heeft vorige week besloten tot de toelating van de nieuwe middelen Property 180SC en Metric.
-
Drie middelen tegen slakken toegelaten
30-05-2017 - Het College voor de toelating van gewasbeschermingsmiddelen en biociden (Ctgb) heeft drie slakkenbestrijdingsmiddelen op basis van laag-risicostof toegelaten.
-
Ctgb legt twee ontwerpbesluiten ter inzage
30-05-2017 - ?Het College voor de toelating van gewasbeschermingsmiddelen en biociden (Ctgb) besluit binnenkort over toelating van twee nieuwe middelen op basis van werkzame stoffen die niet eerder in...
-
Drie nieuwe middelen toegelaten
30-05-2017 - Het College voor de toelating van gewasbeschermingsmiddelen en biociden (Ctgb) heeft drie nieuwe middelen goegekeurd.
-
Ctgb laat twee nieuwe middelen toe
02-05-2017 - Het College voor de toelating van gewasbeschermingsmiddelen en biociden (Ctgb) heeft in de laatste bijeenkomst twee middelen toegelaten: Spandis en Quad-Glob 200 SL.
-
Vrijstelling Dazide Enhance toegekend
24-04-2017 - Voor het knelpunt groeiregulatie voor de onbedekte pot- en containerteelten van hortensia, viburnum, chrysant, azalea en aster is de vrijstelling toegekend voor het middel Dazide Enhance...
Meest bekeken
Meest gelezen
Kennispartners
Vacatures
Redacteur Business & Markten
Nieuwe Oogst - Zwolle, Nederland
Agriwerker
Stichting Proefboerderijen Noordelijke Akkerbouw - Munnekezijl, Noordoost-Friesland
Agrarisch Onderzoeker/Projectleider
Stichting Proefboerderijen Noordelijke Akkerbouw - Munnekezijl En Nieuw Beerta
Agrarisch medewerker
KWS Benelux BV - Nagele (Noordoostpolder)
Manager Proefvelden
KWS Benelux BV - Nagele (Noordoostpolder)
Thema's
Weer
-
Vrijdag18° / 12°90 %
-
Zaterdag18° / 13°35 %
-
Zondag18° / 12°15 %